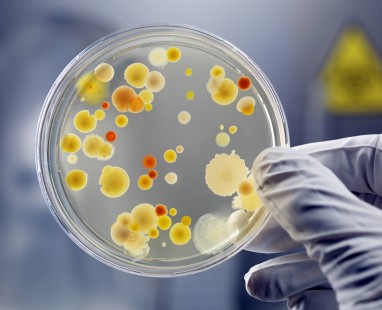
Gloved hand examining bacterial colonies growing in petri dish

We’ve noticed you’re visiting from NZ. Click here to visit our NZS site.
What we do
We transform complex challenges into practical solutions through expert policy development and policy analysis. Our deep policy implementation experience bridges the gap between government and business and delivers solutions that work.
We engage meaningfully with stakeholders, analyse complex evidence and develop clear standards and guidelines.
The result? Better decision-making and more effective policy outcomes.
-

-

-



Policy Development + Implementation
We provide expert evidence-based policy advice across the policy lifecycle, from defining problems to conducting literature reviews, evaluating options and implementing recommendations. Our analysis, supported by rigorous research and stakeholder engagement, makes it easy for decision-makers to find a clear way forward.
-
Cost-benefit analysis - systematically evaluating potential government policy including its social, economic and regulatory impact.
-
International research - analysing global policy trends and adapting successful government policies for Australia's unique context.
-
Guidance documents - developing practical frameworks to implement policy changes effectively and efficiently.

Related Projects
Evidence-Based Clinical Pathway for Biotoxin-Related Illnesses
Read More

Regulatory Development and Stewardship
We support best practice regulation through end-to-end services, including comprehensive impact assessments. Our integrated approach combines thorough cost-benefit analysis and risk management across sectors - from tobacco control and food safety to workers compensation and national parks.
Regulatory options development
Creating feasible government policies that balance risk management with regulatory burden, informed by research and industry insights.
Impact assessment and cost-benefit analysis
Systematically evaluating social, economic and regulatory impacts of government policies to strengthen risk management, and evidence-based decision making.
Regulatory review
Assessing the effectiveness of regulation through risk management frameworks, evaluating compliance burden and recommending practical improvements.

Stakeholder Engagement + Submissions Analysis
Since 2023, Allen + Clarke has analysed over 435,000 written stakeholder submissions in response to consultations and hundreds of thousands of stakeholder interactions through comprehensive stakeholder engagement processes utilising thematic analysis. Our proven stakeholder mapping approach ensuring that the voice of Aboriginal and/or Torres Strait Islander peoples, other priority populations and diverse communities are heard.
-
Designing public engagement strategies - developing targeted consultation approaches through stakeholder analysis and mapping that drives meaningful participation.
-
Leading stakeholder engagement - capturing diverse perspectives through structured focus groups, interviews, workshops and targeted engagement activities.
-
Undertaking comprehensive thematic analysis – transforming stakeholder insights into clear, actionable recommendations that strengthen decision-making.

Our Process

Understand
We dig deeper to reframe challenges and uncover what truly matters.

Plan
We create tailored blueprints that save time and drive success.

Deliver
We communicate transparently while managing risk with empathy and agility.

Review
We test findings with stakeholders to eliminate surprises and gain insights.

Close
We capture lessons and celebrate achievements to continuously improve.
Standards + Guidelines
We combine rigorous literature reviews with qualitative and quantitative research to develop evidence-based guidelines and standards. Our collaborative mixed methods research approach has delivered practical guidance across complex areas including management of Debilitating Symptom Complexes Attributed to Ticks, counselling and psychotherapy, and ecologically safe burials.
-
Evidence synthesis – combining qualitative and quantitative research to build robust, implementable standards that work.
-
Analysis of comparative guidelines – applying advanced research design to deliver literature reviews that cut through complexity and identify actionable solutions.
-
Development of standards and guidelines – transforming mixed methods research into practical guidance that helps your organisation deliver best stakeholder outcomes.

Frequently Asked Questions
How do you handle politically sensitive issues?
Our team have experience working on both politically and commercially sensitive issues. For any sensitive issue we ensure there are clear expectations up-front and robust risk management processes in place. Our team ensures there is balanced consideration of different viewpoints and options, and present findings and recommendations in a way that acknowledges the political realities while remaining evidence-based.
How do you maintain objectivity when analysing stakeholder submissions?
Our team have extensive experience with analysing submissions and practice with maintaining objectivity. Our submissions analysis process uses a structured analytical methodology, and we often incorporate multiple analysts or reviewers to provide quality assurance checks. Our approach aims to present the views of stakeholders independently, with any critical analysis or insight clearly delineated from stakeholder viewpoints.
Can you help us to develop legal standards or guidelines?
Yes, our team have expertise in developing legally robust standards and guidelines. We work closely with your legal advisors to ensure that any standards or guidelines are practical and have the right balance of certainty and flexibility.
How do you approach developing policy in areas with limited evidence or precedent?
In emerging areas we develop theoretical frameworks, complete first principles analysis, and consider what evidence from similar or related fields or other jurisdictions may be able to tell us. We ensure that any solutions we design are flexible to adapt as evidence emerges or the situation changes.
How do you handle policy projects that span multiple government agencies?
We know that projects that span multiple government agencies have unique challenges. We help clients to navigate this complexity by identifying interdependencies, establishing joint working arrangements and ensuring consistent communications. We have specific experience facilitating collaborative policy development across agency boundaries.



